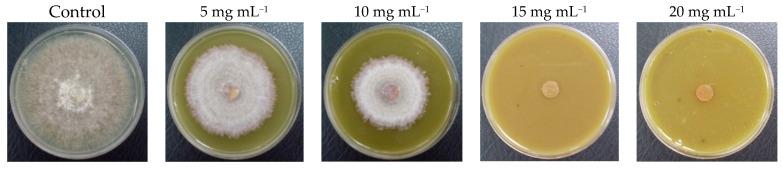
https://cdn.ncbi.nlm.nih.gov/pmc/blobs/9d5c/10893491/d63095df30e4/plants-13-00497-g005.jpg

用高效液相色谱和质谱法(HPLC-MS)对威尔德氏(Vahl ex Willd.)植物中酚类化合物的抗氧化和抗真菌活性及特性研究
Antioxidant and Antifungal Activities and Characterization of Phenolic Compounds Using High-Performance Liquid Chromatography and Mass Spectrometry (HPLC-MS) in Vahl ex Willd.
作者信息
Schneider Carlos, González-Reyes Makarena, Vergara Carola, Fuica-Carrasco Camila, Zapata Patricio
机构信息
Departamento de Ciencias y Tecnología Vegetal, Escuela de Ciencias y Tecnologías, Universidad de Concepción, Campus Los Angeles, Los Angeles 4440000, Chile.
Departamento de Análisis Instrumental, Facultad de Farmacia, Universidad de Concepción, Campus Concepción, Concepción 4030000, Chile.
出版信息
Plants (Basel). 2024 Feb 9;13(4):497. doi: 10.3390/plants13040497.
In searching for compounds with antioxidant and antifungal activity, our study focused on the subshrub species Vahl ex Willd. (Ericaceae). We measured the antioxidant activity of its methanolic extract (MEE) obtained from the aerial parts (leaves and stems) and of its methanolic extract (MEF) obtained from the lyophilized fruits. The antioxidant activity of the MEE and MEF was evaluated in vitro via a 2,2-Diphenyl-1-picrylhydrazyl (DPPH) free radical and 2,2'-Azino-bis-(3-ethylbenzothiazoline-6-sulfonic acid) diammonium salt (ABTS) cationic radical. The results were expressed in gallic acid and Trolox equivalents for the DPPH and ABTS assays, respectively. The antioxidant activities, for the DPPH and ABTS assays, were also evaluated by considering the IC values. Concerning the antioxidant activity, the total phenolic content (TPC) in the MEE and MEF was determined using the Folin-Ciocalteu method. Polyphenols contained in the leaves, stems, and fruits of were determined qualitatively by employing high-performance liquid chromatography coupled with mass spectrometry (HPLC-MS) analysis. The antifungal activity of the MEE obtained from the aerial parts of was tested against . The results of IC values measured by the DPPH and ABTS methods with MEE were 0.4145 ± 0.0068 mg mL and 0.1088 ± 0.0023 mg mL, respectively, and the IC values for MEF were 6.4768 ± 0.0218 mg mL and 0.7666 ± 0.0089 mg mL measured by the DPPH and ABTS methods, respectively. The HPLC-MS analysis revealed the presence of anthocyanins, phenolic acids derivatives, and flavonols. In vitro, mycelial growth of this fungus was reduced from 90% to nearly 100% in the presence of MEE. The observed antifungal effect is related to the presence of the abovementioned phenols, detected in the MEE.
在寻找具有抗氧化和抗真菌活性的化合物时,我们的研究聚焦于杜鹃花科的亚灌木物种Vahl ex Willd.。我们测定了从地上部分(叶和茎)获得的甲醇提取物(MEE)以及从冻干果实获得的甲醇提取物(MEF)的抗氧化活性。通过2,2-二苯基-1-苦基肼(DPPH)自由基和2,2'-偶氮二(3-乙基苯并噻唑啉-6-磺酸)二铵盐(ABTS)阳离子自由基体外评估MEE和MEF的抗氧化活性。结果分别以没食子酸当量和Trolox当量表示DPPH和ABTS测定结果。还通过考虑IC值评估DPPH和ABTS测定的抗氧化活性。关于抗氧化活性,使用福林-西奥尔特法测定MEE和MEF中的总酚含量(TPC)。通过高效液相色谱-质谱联用(HPLC-MS)分析定性测定Vahl ex Willd.的叶、茎和果实中所含的多酚。测试了从Vahl ex Willd.地上部分获得的MEE对[具体真菌名称未给出]的抗真菌活性。用MEE通过DPPH和ABTS方法测得的IC值分别为0.4145±0.0068 mg/mL和0.1088±0.0023 mg/mL,通过DPPH和ABTS方法测得的MEF的IC值分别为6.4768±0.0218 mg/mL和0.7666±0.0089 mg/mL。HPLC-MS分析表明存在花青素、酚酸衍生物和黄酮醇。在体外,在MEE存在下,这种真菌的菌丝体生长从90%降低到近100%。观察到的抗真菌作用与在MEE中检测到的上述酚类物质的存在有关。